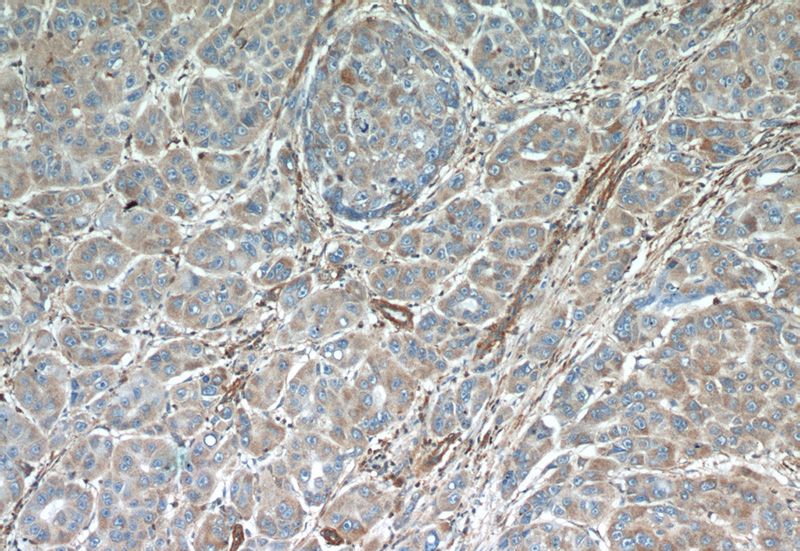
Immunohistochemical of paraffin-embedded human liver cancer using Catalog No:108094(ANXA3 antibody) at dilution of 1:50 (under 10x lens)
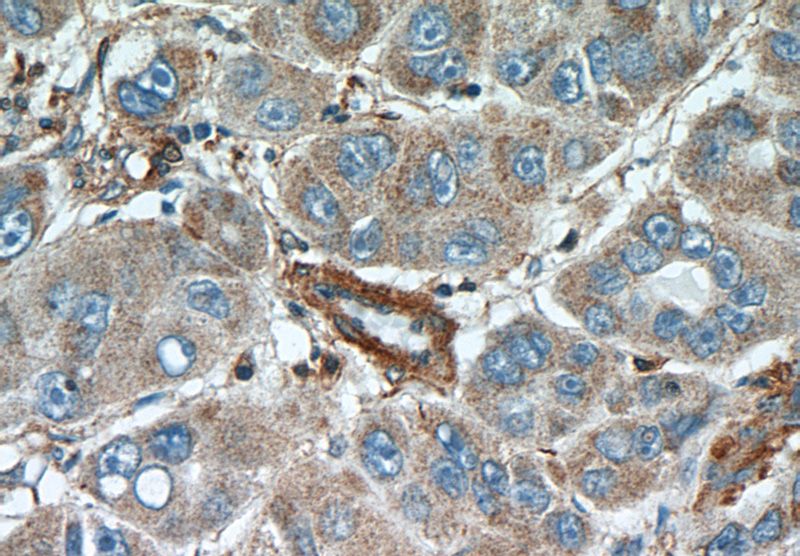
Immunohistochemical of paraffin-embedded human liver cancer using Catalog No:108094(ANXA3 antibody) at dilution of 1:50 (under 40x lens)

-
Product Name
Annexin A3 antibody
- Documents
-
Description
Annexin A3 Rabbit Polyclonal antibody. Positive IHC detected in human liver cancer tissue, human colon cancer tissue, human liver tissue. Positive IP detected in mouse liver tissue. Positive WB detected in HepG2 cells, HEK-293 cells, human brain tissue, human liver tissue. Observed molecular weight by Western-blot: 36 kDa
-
Tested applications
ELISA, IHC, IP, WB
-
Species reactivity
Human,Mouse,Rat; other species not tested.
-
Alternative names
35 alpha calcimedin antibody; Annexin 3 antibody; annexin A3 antibody; Annexin III antibody; ANX3 antibody; ANXA3 antibody; LipOCortin III antibody; PAP III antibody
-
Isotype
Rabbit IgG
-
Preparation
This antibody was obtained by immunization of Annexin A3 recombinant protein (Accession Number: NM_005139). Purification method: Antigen affinity purified.
-
Clonality
Polyclonal
-
Formulation
PBS with 0.1% sodium azide and 50% glycerol pH 7.3.
-
Storage instructions
Store at -20℃. DO NOT ALIQUOT
-
Applications
Recommended Dilution:
WB: 1:200-1:2000
IP: 1:200-1:2000
IHC: 1:20-1:200
-
Validations

HepG2 cells were subjected to SDS PAGE followed by western blot with Catalog No:108094(ANXA3 Antibody) at dilution of 1:600
Immunohistochemical of paraffin-embedded human liver cancer using Catalog No:108094(ANXA3 antibody) at dilution of 1:50 (under 10x lens)
Immunohistochemical of paraffin-embedded human liver cancer using Catalog No:108094(ANXA3 antibody) at dilution of 1:50 (under 40x lens)

IP Result of anti-ANXA3 (IP:Catalog No:108094, 4ug; Detection:Catalog No:108094 1:500) with mouse liver tissue lysate 4000ug.
-
Background
Annexin A3 (Anxa3), also named as lipocortin3, placental anticoagulant protein3 (PAP-III), belongs to annexin family. Annexins are calcium-dependent phospholipids-binding high-abundant intracellular proteins. ANXA3 has been reported to play crucial roles in a diverse range of molecular and cellular processes, including ion channel regulation, anticoagulation, anti-inflammation, vesicle traffick-ing, signal transduction, cell migration, and cell proliferation. It also exhibits important roles in cancer progression, metastasis, and drug resistance.
-
References
- Nishiura H, Yamanegi K, Kawabe M, Kato-Kogoe N, Yamada N, Nakasho K. Annexin A3 plays a role in cytoplasmic calcium oscillation by extracellular calcium in the human promyelocytic leukemia HL-60 cells differentiated by phorbol-12-myristate-13-acetate. Experimental and molecular pathology. 97(2):241-6. 2014.
- Liao CC, Lin YL, Kuo CF. Effect of high-fat diet on hepatic proteomics of hamsters. Journal of agricultural and food chemistry. 63(6):1869-81. 2015.
- Nishiura H, Yamanegi K, Kawabe M, Kato-Kogoe N, Yamada N, Nakasho K. The roles of ribosomal protein S19 C-terminus in a shortened neutrophil lifespan through delta lactoferrin. Immunobiology. 220(9):1085-92. 2015.
- Jia X, Yin L, Feng Y. A dynamic plasma membrane proteome analysis of alcohol-induced liver cirrhosis. Proteome science. 10(1):39. 2012.
Related Products / Services
Please note: All products are "FOR RESEARCH USE ONLY AND ARE NOT INTENDED FOR DIAGNOSTIC OR THERAPEUTIC USE"
